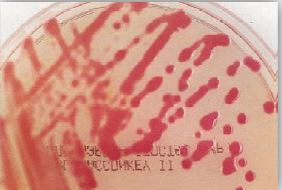
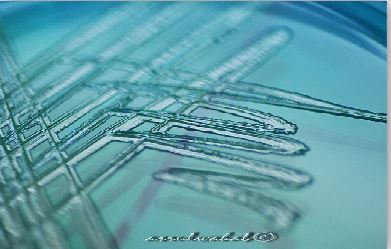

النبات
النبات
 الحيوان
الحيوان
 الأحياء المجهرية
الأحياء المجهرية
 علم الأمراض
علم الأمراض
 التقانة الإحيائية
التقانة الإحيائية
 التقنية الحيوية المكروبية
التقنية الحيوية المكروبية
 التقنية الحياتية النانوية
التقنية الحياتية النانوية
 علم الأجنة
علم الأجنة
 الأحياء الجزيئي
الأحياء الجزيئي
 علم وظائف الأعضاء
علم وظائف الأعضاء
 الغدد
الغدد
 المضادات الحيوية
المضادات الحيوية|
أقرأ أيضاً
التاريخ: 2025-01-11
التاريخ: 2025-02-16
التاريخ: 12-7-2019
التاريخ: 7-9-2016
|
Pseudomonas Spp
خلايا هذا الجنس البكتيري عبارة عن عصويات هوائية بحجم 0.6 عرض و 2 ميكرومتر طول، وهي سالبة لصبغة جرام غير مكونة للأبواغ . وهو متحرك بواسطة أسواط (سوط أو اثنين) تتواجد في قطبي الخلية كما أن بعض سلالات النوع البكتيري Pseudomnas aeruginosa قد يكون حافظة ويعتبر من أهم الأجناس البكتيرية الممرضة وذلك من أصل 200 نوع من هذا الجنس وله القدرة على النمو في درجة حرارة 42-37 درجة مئوية ويفرز صبغتين قابلتين للذوبان وهما صبغة pyocyanin الذي يكسبها اللون الأزرق عند تنميته في المعمل وصبغة Pyoverdin الذي يكسبه اللون الأصفر المخضر وهذه الصبغة تفرز بكثرة في الوسط الغذائي الذي يحتوي على مقدار قليل من الحديد وهناك نوعان آخران من الصبغات يفرزهم هذا الجنس البكتيري وهما صبغة pyorubrin الذي يكسبها اللون الأحمر وصبغة Melanin الذي يكسبها اللون البني ومن المعروف قدرة هذه البكتيريا على مقاومة المضادات الحيوية.

خلايا النوع البكتيري P. aeruginosaبصبغة جرام
يتواجد هذا الجنس البكتيري في القناة الهظمية والمياه والتربة ومياه الصرف الصحي وله القدرة على التواجد في البيئات الرطبة للمستشفيات مثل أحواض الغسيل وأدوات تنظيف الأرضيات ، كما له القدرة على النمو في قطرات العين مثل quaternary ammonium compound والمحلول الملحي وبعض مواد التطهير.

الامراضية :
نظراً لتواجد هذا الجنس البكتيري في المياه فهو المسئول على حوالي 10% من إصابات عدوى المستشفيات حيث تم عزل أنواع كثيرة من هذا الجنس البكتيري من المياه بالإضافة إلى النوع البكتيري Ps. aeruginosa مثل النوع البكتيري Ps. fluorescens والنوع البكتيري Ps. alcaligenes والنوع البكتيري Ps. cepacia والنوع البكتيري ps.allei والنوع البكتيري Ps. maltophila والنوع البكتيري Ps. flava والنوع البكتيري Ps. pseudoflava والنوع البكتيري Ps. palleroni والنوع البكتيري Ps. rhodos والنوع البكتيري Ps. echinoids والنوع البكتيري radiora . Psوكذلك النوع البكتيري Ps. mesophilica . ويلعب الجنس البكتيري Pseudomonas Spp دوراً كبيراً في إحداث الإصابات في مياه الترفيه الملوثة وغالباً ما يتواجد النوع البكتيري Ps. aeruginosa في المياه الملوثة بالملوثات الغائطية.
أغلب الإصابات اتي يحدثها النوع البكتيري Ps. aeruginosa تكون انتهازية وتسبب ما يعرف بعدوى المستشفيات وهذه الإصابة تحدث في الأشخاص المصابين بخلل في الجهاز المناعي ومن الصعب الوقاية من هذه الإصابة حيث أن هذا النوع البكتيري مقاوم للعديد من المضادات الحيوي ومن أهم هذه الاصابات :
- الإصابات الجلدية وتحديداً في مواضع الحروق والجروح والتقرحات وقد ينتج عن ذلك حدوث تجرثم للدم.
- التهاب المسالك البولية وخاصة بعد استعمال القسطرة catheterization أو نتيجة الإصابة المزمنة.
- الإصابات الصدرية وخاصة عند الأشخاص المصابين بمرض cystic fibrosis .
- التهاب الاذن الخارجية otitis externa وكذلك إصابات العيون والذي غالباً ما يلي الحوادث او العمليات الجراحية.

التهاب الاذن الخارجية otitis externa
وتحدث هذه الإصابات بعد دخول البكتيريا الممرضة من خلال الجلد أو الغشاء المخاطي المخدوش أو من خلال إدخال أداة ملوثة بهذه البكتيريا الممرضة فتلتصق بالغشاء المخاطي بواسطة الأهذاب Pili وتتكاثر وتبدأ في إفراز الإنزيمات الخارجية extracellular enzymes مثل انزيمات elsatases و Proteases وانزيمين محللين للدم هما phospholipase غير المقاوم للحرارة و glycolipid المقاوم للحرارة كما ينتج بعض الذيفانات الخارجية exotoxins مثل exotoxin الذي يسبب تلف الانسجة والذي يعتبر قاتل إذا ما حقن في حيوانات التجارب، وهذا الذيفان يقوم بمنع تصنيع البروتين بنفس الطريقة التي يقوم بها ذيفان النوع البكتيري C. diphtheria رغم أنه لا يشبهه في التركيبة.
ولا يمكن علاج الحالات المصابة بالنوع البكتيري Ps. Aeruginosa باستعمال مضاد حيوي واحد حيث أن فرص العلاج ستكون ضئيلة جداً، ويمكن استعمال المضاد الحيوي penicillin مع المضاد الحيوي pipracllin أو المضاد الحيوي mezlocillin أو المضاد الحيوي pipracillin مع أحد المضادات الحيوية من مجموعة aminoglycoside في الغالب المضاد الحيوي gentamicin او المضاد الحيوي toberonamicin أو المضاد الحيوي amikacin كما يمكن استعمال المضاد الحيوي aztreonam والمضاد الحيوي imipernem التابعين لمجموعة cephalosporins.
التشخيص المعملي :
يعتمد اختبار العينة اللازمة لإجراء التحاليل التشخيصية على نوع الإصابة فقد تكون عينة بول أو صديد أو بصاق أو دم ليتم إجراء المزرعة البكتيرية.
يمكن التعرف على المستعمرات النامية بملاحظة تكون صبغة pyocyanin ذات اللون الأخضر المزرق و pyoverdin المسئول على اللون اللاصق للمستعمرات النامية وهي صبغة خضراء مصفرة مع التأكيد على أن بعض السلالات ليس لها القدرة على إنتاج هذه الصبغات كما يمكن ملاحظة الرائحة المتميزة للمستعمرات النامية نتيجة تكون المركب 2-aminoactophenone .
ــ الوسط الغذائي Blood agar : المستعمرات البكتيرية النامية كبيرة الحجم ، مسطحة وهي غالباً لها القدرة على إحلال الدم الحمراء وحمالي 90% من السلالات لها القدرة على انتاج الصبغة التي تنتشر في الوسط الغذائي مما يكسبه لون أزرق مخضر غامق مع تكون طبقة لماعة medtallic على سطح بكتيرية صغيرة الحجم أو لزجة وعند ترك المستعمرات النامية في درجة الغرفة فإن الصيغة ستنتج بكمية كبير.

ــ الوسط الغذائي MacConkey agar : المستعمرات البكتيرية النامية ليس لها القدرة على تخمير سكر اللاكتوز ولها القدرة على استهلاك peptone مما يؤدي لتكون الأمونيا وينتج عن ذلك ظهور مستعمرات بكتيرية عديمة الون وقد يميل لونها من الذهبي إلى البني مع وجود لون معتم في منتصف المستعمرات البكتيرية.

مستعمرات Ps. aeruginosa على الوسط الغذائي MacConkey agar
مستعمرات Burkholderia (Ps). على الوسط الغذائي MacConkey agar
ــ الوسط الغذائي CLED : المستعمرات البكتيرية النامية ستكون بلون أخضر وبأقل كمية من الصبغة المنتجة.
مستعمرات Ps. aeruginosa على CLED agar
ــ الوسط الغذائي KIA : الوسط الغذائي المائل Slope سيكون بلون وردي محمر في الغالب بمظهر لماع وقاع الانبوبة كذلك بنفس اللون مع عدم تكون الغاز وكبريتيد الهدروجين.
الاختبارات المعملية :
بهذه الاختبارات الثلاثة يمكن التعرف على الجنس البكتيري pseudomonas Spp كما أن إمكانية النمو في درجة حرارة 42 درجة مئوية يميز النوع Ps. aeruginosa عن بقية الأنواع التي تتبع نفس الجنس البكتيري مثل النوع البكتيري Ps.aeruginsa عن بقية الأنواع التي تتبع نفس الجنس البكتيري مثل النوع البكتيري Ps. putoda والنوع البكتيري Ps. fluorescens.

(1) : أغلب السلالات تعطي نفس النتيجة.
(2) : أغلب السلالات تنتج صبغة pyocyanin وصبغة fluorescein.
(3) : ينتج فقط صبغة fluorescein.



|
|
|
|
التوتر والسرطان.. علماء يحذرون من "صلة خطيرة"
|
|
|
|
|
|
|
مرآة السيارة: مدى دقة عكسها للصورة الصحيحة
|
|
|
|
|
|
|
نحو شراكة وطنية متكاملة.. الأمين العام للعتبة الحسينية يبحث مع وكيل وزارة الخارجية آفاق التعاون المؤسسي
|
|
|